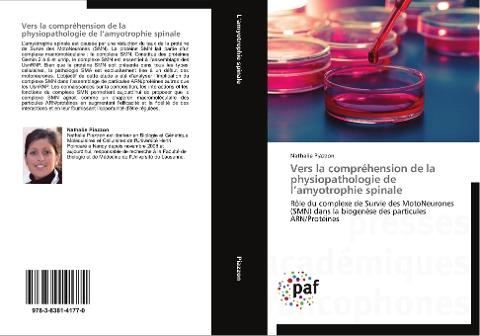
Vers la compréhension de la physiopathologie de l'amyotrophie spinale

Autorenfreundlich Bücher kaufen?!

Beschreibung
L¿amyotrophie spinale est causée par une réduction du taux de la protéine de Survie des MotoNeurones (SMN). La protéine SMN fait partie d¿un complexe macromoléculaire : le complexe SMN. Constitué des protéines Gemin 2 à 8 et unrip, le complexe SMN est essentiel à l¿assemblage des UsnRNP. Bien que la protéine SMN soit présente dans tous les types cellulaires, la pathologie SMA est exclusivement liée à un défaut des motoneurones. L¿objectif de cette étude a été d¿analyser l¿implication du complexe SMN dans l¿assemblage de particules ARN/protéines autres que les UsnRNP. Les connaissances sur la composition, les interactions et les fonctions du complexe SMN permettent aujourd¿hui de proposer que le complexe SMN agirait comme un chaperon macromoléculaire des particules ARN/protéines en augmentant l'efficacité et la fidélité de ces interactions et en leur fournissant l¿opportunité d¿être régulées.
Rôle du complexe de Survie des MotoNeurones (SMN) dans la biogenèse des particules ARN/Protéines
Details
| Verlag | Presses Académiques Francophones |
| Ersterscheinung | 21. Mai 2014 |
| Maße | 22 cm x 15 cm x 1.9 cm |
| Gewicht | 489 Gramm |
| Format | Softcover |
| ISBN-13 | 9783838141770 |
| Seiten | 316 |